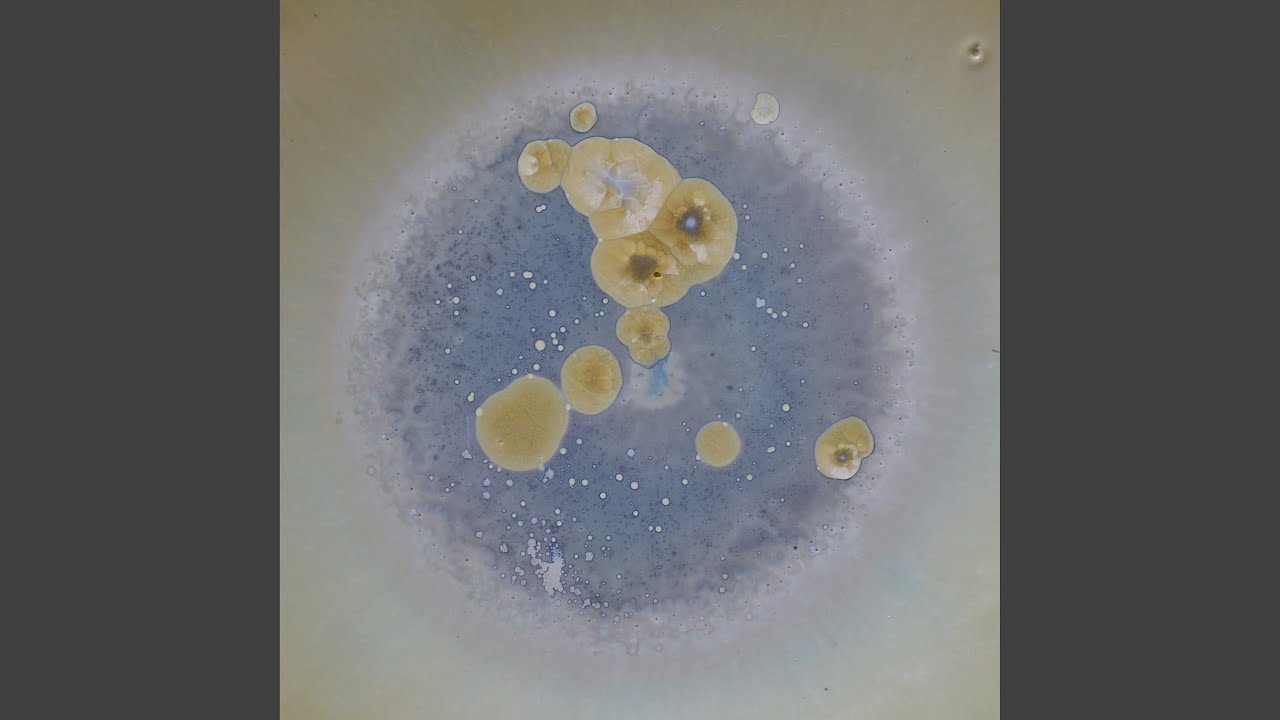

Melodyjność
W jakim stopniu utwór ma wyraźną i zapadającą w pamięć melodię, która podąża za dobrze zdefiniowanymi wzorcami muzycznymi. Utwory o wysokiej melodyjności zazwyczaj charakteryzują się wyraźnymi i zapadającymi w pamięć liniami instrumentalnymi lub wokalnymi.
Akustyczność
Miara tego, jak bardzo utwór opiera się na instrumentach akustycznych (np. fortepian, gitara, skrzypce, perkusja, saksofon) zamiast elektronicznych lub cyfrowo syntetyzowanych.
Valence
Pozytywny wydźwięk muzyczny lub emocjonalny ton przekazywany poprzez elementy harmoniczne i rytmiczne utworu. Wysoka intensywność emocjonalna odpowiada uczuciom szczęścia, podekscytowania i euforii, podczas gdy niska intensywność emocjonalna kojarzy się ze smutkiem, gniewem lub melancholią.
Taneczność
Połączenie czynników, takich jak stabilność tempa, wzorce rytmiczne i akcentowanie rytmu, które decydują o tym, jak bardzo utwór nadaje się do tańca. Utwór „do tańca” może charakteryzować się spójnym tempem, powtarzalną strukturą muzyczną i mocnymi akcentami na początku taktu.
Energia
Postrzegana intensywność utworu, na którą mogą wpływać tempo, dynamika i zwartość muzyczna. Utwór o wysokiej energii może mieć dynamiczny rytm i bogatą instrumentację, podczas gdy utwór o niskiej energii może być muzycznie oszczędny i charakteryzować się wolniejszym tempem.
BPM123